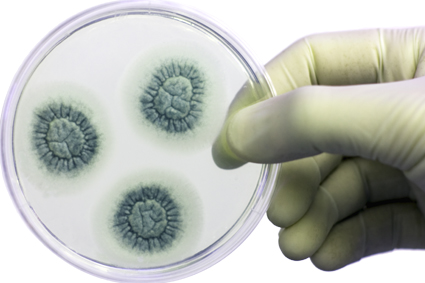
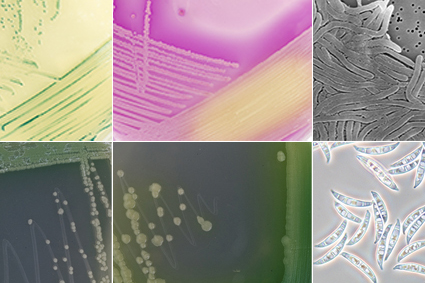

Services
Supply of strains

Preservation of microbial resources: long-term storage and strain management

Research on microbial strains: genomics, functional traits and biotech applications

Online services: digital access to strain information and metadata

Identification of microbial isolates: molecular and biochemical methods

Development of algal research and biotechnology solutions (Marine Agronomy and Blue Biotechnology)
Training programs

Consultancy
